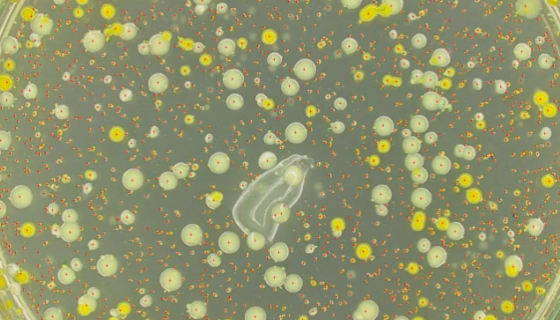
荧光假单胞菌的特点与作用及应用领域！
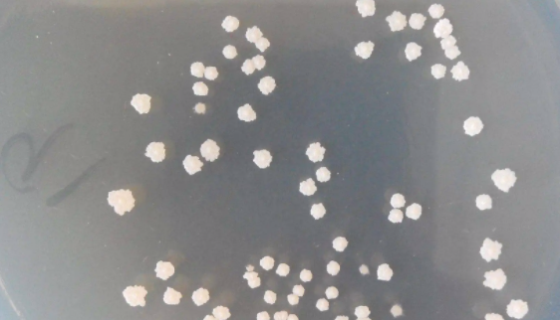
解淀粉芽孢杆菌知识解析及其作为益生菌的应用！

荧光假单胞菌的特点与作用及应用领域!
荧光假单胞菌是一种重要的植物病害生防菌和根际促生菌(PGPR...

产乙酸嗜蛋白质菌的培养条件与保藏方法!
产乙酸嗜蛋白质菌是Proteiniphilum属的微生物,原...

小鼠肾小球系膜细胞永生化原代培养的实验技巧!
肾小球系膜细胞(MCs)是肾小球最主要的细胞之一,具有分泌细...

ATCC 27844 人葡萄球菌的保藏条件与注意事项!
人葡萄球菌是Staphylococcus属的微生物,原产地为...
解淀粉芽孢杆菌知识解析及其作为益生菌的应用!
解淀粉芽孢杆菌属于芽孢杆菌属,是一种具有广谱抑菌活性的细菌,...

肺炎链球菌的性质、用途与生产工艺!
肺炎链球菌属于链球菌科,链球菌属,俗称肺炎球菌或肺炎双球菌。...

SHP-77人小细胞肺癌细胞的培养步骤与处理方法!
SHP-77 保留了SCLC的重要特征,具有稳定的生物化学特...

人主动脉平滑肌细胞的生理功能与主要用途!
人主动脉平滑肌细胞在心血管疾病发生、发展中具有重要作用,以人...

人皮脂腺细胞SZ95的培养步骤与注意事项!
SZ95人皮脂腺细胞的培养步骤与注意事项有哪些?